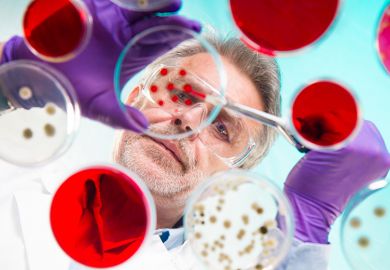

Browse the full results of the World University Rankings 2021
“This is the most complex problem I have ever dealt with,” says University of California, Berkeley chancellor Carol Christ of the Covid-19 pandemic.
“It’s multidimensional, you are working in a situation in which there are so many unknowns as well as things that are unpredictable, and you’re doing it all virtually.”
It would be an understatement to say that 2020 has been a tumultuous year for global higher education and, in many ways, the future for the sector looks bleak.
Some US universities have already permanently closed or merged with other institutions in the wake of the pandemic, while research by the Institute for Fiscal Studies in July suggests that about a dozen UK universities face going bust in the long run as a result of the crisis and in particular reduced tuition fee income from international students.
One UK vice-chancellor warned that many universities in the country were braced for a 50 per cent drop in overseas fee income in the coming academic year, and a May study concluded that the equivalent of 21,000 full-time university staff in Australia risked losing their jobs before the end of the year, including at least 7,000 researchers.
At the same time, the work of higher education institutions has become more prominent than ever. A handful of the globe’s top universities were, of course, already household names, but this year their research on vaccines and coronavirus treatments has been watched by the world.
While no universities will be immune to the financial and operational challenges brought by the pandemic, will the research prominence of some leading universities help mitigate the potential damage they face? And, beyond the societal reward of their scholarship, what benefits might their research success bring to the institutions themselves?
Maggie Dallman, vice-president (international), associate provost (academic partnerships) and professor of immunology at Imperial College London, which ranks 11th in the 2021 World University Rankings, says that the international profile of the institution and the media coverage it has received over the past few months has been “quite extraordinary”.
“[Imperial epidemiologist] Neil Ferguson’s advice to the US government has had a huge impact internationally and hopefully things like the vaccine and rapid tests, which we’re rolling out at the moment, will also be really important around the world,” she says.
Dallman suggests that the broad spectrum of Covid-19-related research at Imperial has differentiated the university from other higher education institutions.
“It’s not just been the vaccine, it’s been the vaccine, the epidemiology, the physical sciences involvement and the engineering involvement with devices as well as the more biological understanding,” she says. “So it’s been an all-college effort, and that’s very much Imperial College DNA, where we bring engineers and medics together and find solutions.”
The shift to remote working has also, perhaps paradoxically, increased the university’s interactions with institutions overseas. Dallman says that she can now fit in two or three meetings with international colleagues a week – a rate that would simply not be possible if she had to get on a plane.
“I’ve been talking to people from all around the world – Australia, China, the US, Canada, and obviously lots in Europe – and the comments I get are always about what an amazing job Imperial has been doing during this period to try and develop the vaccine or do the epidemiology,” she says.
“So I think it really has elevated our profile. Certainly in countries where we have a strong profile it’s been very positive and in countries where we perhaps didn’t have such a strong profile it has also had a major impact.”
Dallman says this elevated profile is “showing every sign of making us a very attractive organisation to work with” and she hopes that it will also help with academic recruitment since “great researchers want to work in institutes with high profiles” and in further diversifying the university’s international student cohort.
Louise Richardson, vice-chancellor of the University of Oxford, which tops the World University Rankings for the fifth consecutive year, shared a similar view in a letter to students and staff in May, before a team of scientists at the institution revealed that its coronavirus vaccine produced a strong immune response.
“It turns out that people cannot get enough of experts, after all,” she wrote.
“Our research profile has never been higher than it is at present. This means that in the aftermath of the crisis we will be able to recruit the best academics and the best students, all attracted by the prospect of working with others of their calibre in an institution committed to creating an environment in which they can do their best work. That has been the secret of our success in the past and will be the key to our success in the future.”

Berkeley’s Christ says she has been “inspired” by the way in which many leading scientists at her university have “shifted the focus of their research to Covid-19”.
The institution, which is ranked seventh in the 2021 World University Rankings, up from joint 13th last year, has already raised $21 million (£16 million) in private philanthropic gifts to fund Covid-related research and Christ says the crisis has “improved not only Berkeley’s research profile but generally made people realise the importance of research universities”.
“Also it’s true generally that at times of economic recession people tend to go back to school,” she adds.
“We went completely remote for our summer sessions, we were prepared to take a big revenue hit and our enrolments are up. So I think we’re seeing, despite the remote delivery of instruction, students themselves putting great value on education.”
The challenge of steering a university during the crisis has also taught Christ some useful leadership lessons.
“It has really reinforced how important communication is. Even if you don’t know [the answer to something], it’s important for the various stakeholders that you’re working with to know that you don’t know. The principal decision-makers on the campus meet constantly – virtually, obviously – to make sure that we’re coordinating the decisions that we’re all making. Making it very clear where accountability lies, where decision-making power lies for various aspects of our operation – that’s been really important. And being able to change when the circumstances change,” she says.
“Sometimes people get paralysed when they don’t know enough to make a perfect decision and this situation has often shown me that it’s really important to make a decision even when you don’t have perfect information. Those are all lessons learned.”
However, despite the positives, Christ says that the financial issues pose “an extremely serious challenge for us”.
As has been the case at other universities, the crisis has resulted in “very sudden revenue losses” in the areas of student housing and dining, athletics and cultural performances – although Christ is hopeful that these parts of the business will recover when Berkeley can return to a more normal mode of operation.
Much more serious, according to Christ, are the pressures on the university’s core budget. These include Covid-related expenses to the tune of $55 million for enhanced cleaning, testing and remote instruction; an expected 10 per cent budget cut by the state of California; and a potential decline in student enrolment.
In many ways Berkeley aims to continue on the path that it set out in its 2018 strategic plan in the wake of the coronavirus. The university’s five priority areas – climate change and environmental justice; the future of human health; economic inequality; the future of democracy; and the relationship between artificial and human intelligence – “seem even more relevant and important in the context of the current pandemic”, according to Christ.
However, remote instruction will be “a far more important piece of our portfolio after the pandemic is over”, she notes. “Some of our faculty say, ‘it’s like I discovered a muscle I didn’t know I had’.”
A trend that is much harder to predict is whether the market for students seeking an education abroad will recover.
“I don’t know when people are going to feel comfortable travelling again, and when travel restrictions will be dropped given the enormous unevenness of how different countries are experiencing the pandemic,” she says.
“Of course, in the US this is exacerbated by the horrible xenophobic administration that we have that is really trying, in so many different ways, to discourage the globalisation of our universities.”

Rachel Kyte, dean of The Fletcher School of international relations at Tufts University, ranked joint 155th, agrees that the uncertainty around the visa regime for international students in the US, including their ability to obtain a work visa post-graduation, “will have a seriously negative effect on student numbers”. Forty per cent of Fletcher’s students are from overseas.
“At the moment students are hesitating because they don’t know whether [policies] will be continued or reversed either under this administration or a future administration. Until that is resolved you’re going to see people looking twice at their original plans, which were to come here, study here and then potentially work here for a while before returning to their home countries,” she says.
“We’re dealing with a potential structural moment of creative destruction, as it were, and we’re dealing with a very negative climate for international students.”
While the US government pulled back from a policy that would have forced overseas students to leave the country if their university moved classes entirely online, after being sued by universities, US institutions say that they anticipate more hits on international students and experts have suggested that Canada might poach those who might otherwise have studied south of the border.
Kyte believes that there is still a desire among students – and especially those studying international affairs – to be part of an international student body involving in-person interaction, noting that the community is “as important in some ways as what you actually learn”.
However, she says that universities will increasingly have to make their content accessible to international students studying remotely.
“We’re going to want to find ways for people to be part of a cohort but then having that content accessible from wherever you are in the world,” she says. “Maybe the lecturers will travel more, and the students less. These are all things to be explored.”
The Fletcher School has moved to fully remote learning for the upcoming autumn semester, partly in a bid to offer an equal education to all of its students, many of whom are unable to travel to the country. But it hopes that it will be able to offer a hybrid model in the spring semester.
Kyte says that the school has long leveraged the importance of place in the pursuit of attracting students. Students on its master’s of transatlantic affairs study half the course at the College of Europe in Belgium and half the course at Tufts in Boston.
“Traditionally, seeing the world from both sides of the Atlantic has been a core strength of that degree,” she says.
“We have a very strong Eurasia programme and we have students who spend a year in Moscow and a year with us. If you’re going to specialise in that relationship then you really do need to be immersed in the culture of both.”
Kyte adds that Asian students increasingly have options to study international affairs within their own region but they have traditionally “wanted the experience of studying in a different region to enhance both their hard and soft skills”.
“Can you replicate all that remotely? I think this is going to be a big question,” she says. “There are lots of things you can do remotely where place isn’t so important. But I think for those things where place is important we’re going to have to find ways to move the content to you but at some point preserve the experience of place.”
Christ agrees that there is still going to be “a great power for place in higher education”, given that the extraordinary growth and development that students undergo during university can be attributed to the college’s community and its place in the world.
“I’ve been amazed about the power and adaptability of virtual tools…but people are just yearning for physical contact,” she says.
“It’s a part of human experience and I think it’s in particular a part of university or college experience, at least as we’ve developed it in the West.”
But Covid-19 is not the only crisis hitting US universities. In Kyte’s view, the sector also has to address the affordability and flexibility of higher education, whether it is delivered remotely or in person, and the need for more technological skills in the workforce.
“Affordability, flexibility and skills were already pushing education in a different direction. Add the fact that [Covid-19] is the first crisis of a potential series of huge disruptions over the next 10 to 15 years that will affect what we teach, who we teach and how we teach it. Those things together mean that our curriculum has to evolve; who we are and who we’re teaching has to evolve – and you see that especially with the Black Lives Matter mobilisation here – and we have to teach in a different way, more flexibly,” she says.
“This is truly a crisis that has to be seen as an opportunity.”
POSTSCRIPT:
Print headline: Accentuate the positive
Register to continue
Why register?
- Registration is free and only takes a moment
- Once registered, you can read 3 articles a month
- Sign up for our newsletter
Subscribe
Or subscribe for unlimited access to:
- Unlimited access to news, views, insights & reviews
- Digital editions
- Digital access to THE’s university and college rankings analysis
Already registered or a current subscriber?